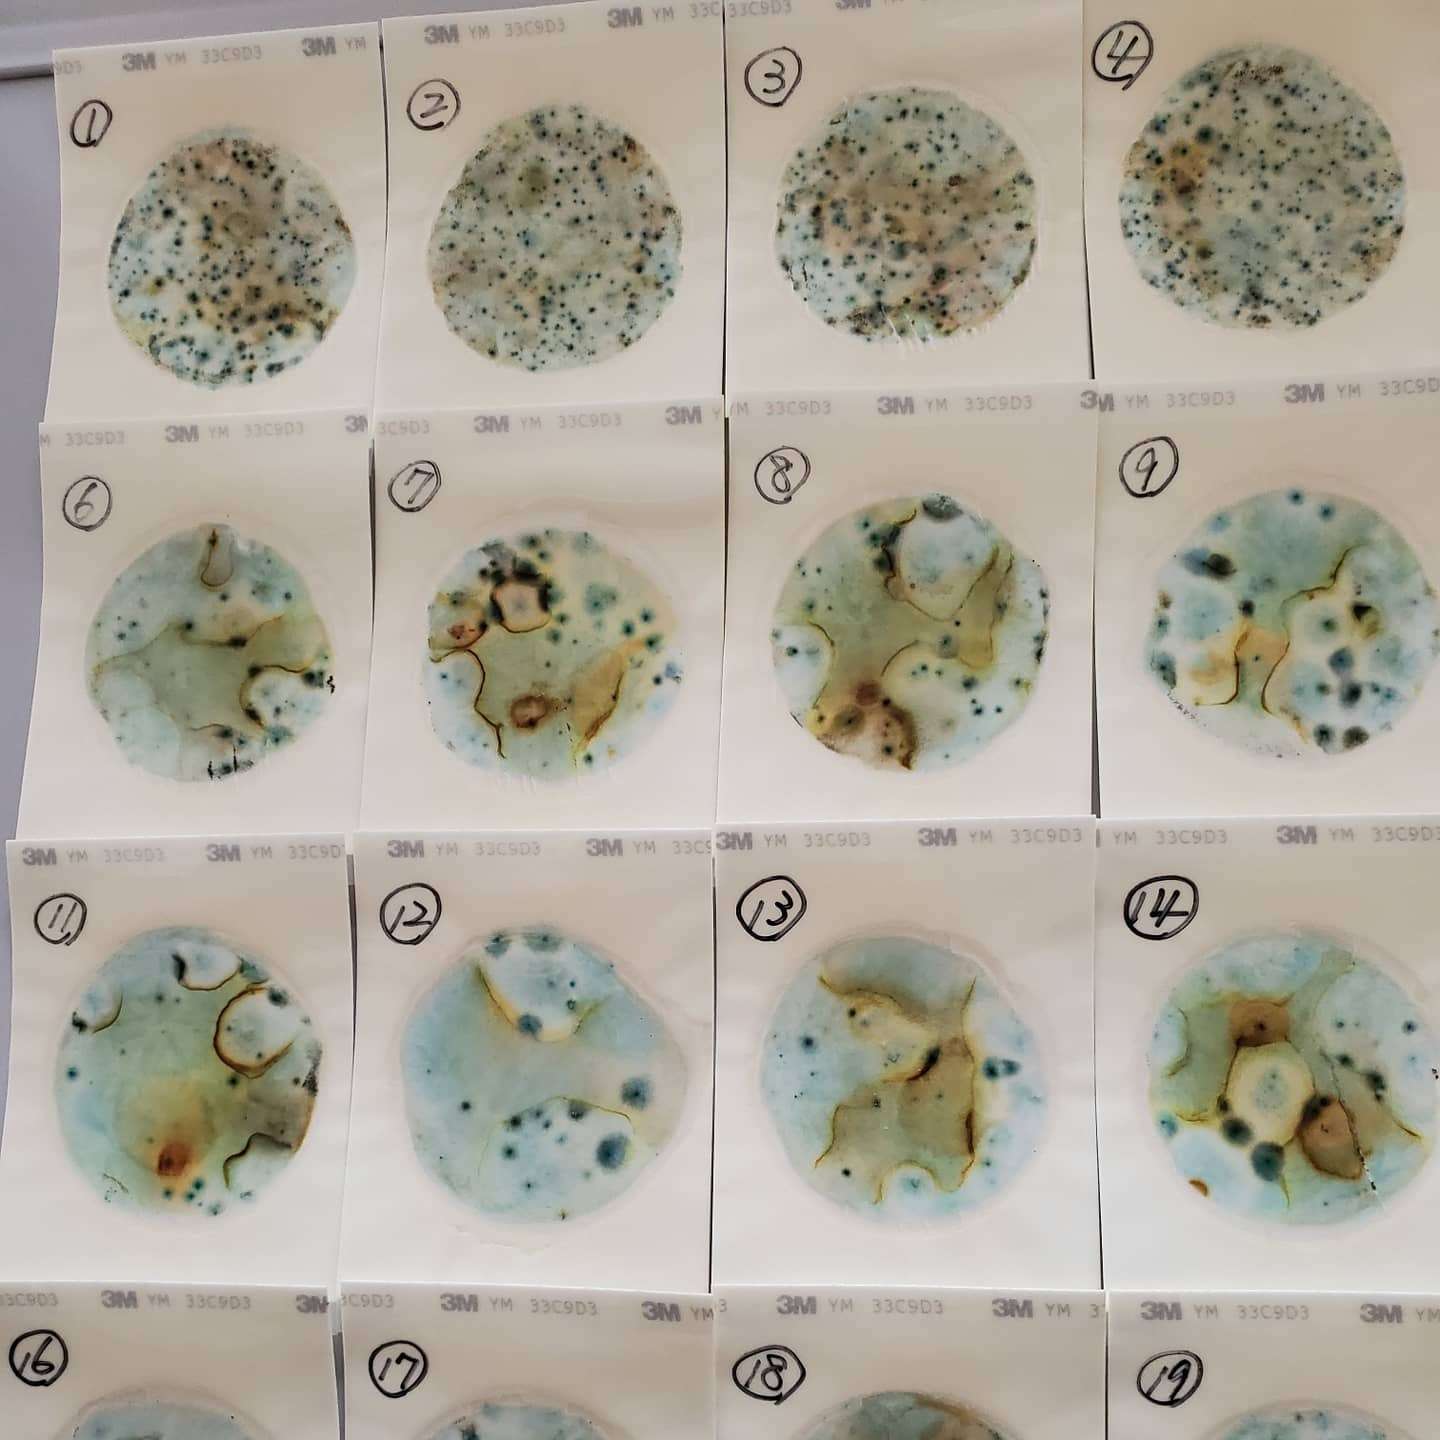

カビ除去の完全ガイド!プロのアドバイスで快適な住環境を取り戻そう
2026/03/23
こんにちは、カビ問題でお悩みの皆さん。突然現れるカビは、見た目の不快さだけでなく、健康への影響も心配ですよね。しかし、ご安心ください。私たちはあなたのお悩みを解決するためにここにいます。このブログでは、カビ問題に関する知識と実践的な対策をご紹介します。専門家のアドバイスや効果的なカビ除去方法など、あなたの快適な住環境を取り戻すための情報が満載です。ぜひご覧ください。一緒にカビ問題を克服し、健康で快適な暮らしを取り戻しましょう。
目次
カビ問題の深刻さと対策の重要性
快適な住環境の追求:カビ問題解決のための積極的な対策
カビ問題は住環境において深刻な悩みとなり得るものです。カビが発生すると、見た目の美しさを損なうだけでなく、健康への影響や建物の劣化など、様々な問題が生じる可能性があります。そのため、カビ問題に対しては積極的な対策が求められます。快適で健康的な住環境を追求するためには、カビ問題を解決するための適切な対策を取る必要があります。
カビが引き起こす様々な問題
カビは湿度や通気不足などの環境条件が整うと繁殖し、壁や天井、床など様々な場所に発生します。カビが増殖すると、まず見た目に影響を及ぼし、美しい住空間を損ねるだけでなく、カビの臭いも広がります。また、カビが成長すると建材や家具、家電などにも損傷を与え、修復や交換の費用がかかる可能性もあります。さらに、カビによるアレルギー症状や呼吸器系の疾患のリスクも存在します。これらの問題は、カビ対策を怠ることでより深刻化する可能性があるため、早期の対策が重要です。
健康への悪影響とそのリスク
カビは微小な胞子を放出し、空気中に拡散します。これらのカビの胞子を吸い込むことで、アレルギー反応を引き起こすことがあります。特にアレルギー体質や免疫力が低下している人々は、カビによるアレルギー症状が現れやすい傾向にあります。また、一部のカビには有害な物質であるマイコトキシンを生成するものもあり、これらの物質に長期間接触することで健康へのリスクが生じる可能性があります。例えば、呼吸器疾患やアレルギー反応、免疫機能の低下などが報告されています。健康を損なわないためにも、カビの発生を予防し、適切に対処する必要があります。
カビ問題は見過ごされがちですが、その深刻性と重要性は言わずもがなです。快適な住環境を維持し、健康を守るためには、カビ問題に積極的に取り組む必要があります。次の章では、具体的なカビ発生の主な原因と予防策についてご紹介します。
カビ発生の主な原因と予防策
湿度と通気の管理でカビの繁殖を防ぐ
カビの発生は、湿度と通気不良が主な原因となっています。湿度が高い環境や十分な換気が行われていない場合、カビは繁殖しやすくなります。この章では、カビ発生の主な原因と予防策について詳しく見ていきましょう。
高湿度環境と通気不良の影響
高湿度環境では、空気中の水分が多く含まれており、カビの成長に適した状態となります。特に、浴室やキッチンなどの水回りは湿度が高く、カビが発生しやすい場所です。また、通気不良な空間では湿気がこもりやすく、湿度が上昇しやすくなります。カビが発生すると、見た目の美観を損ねるだけでなく、カビの胞子や有害な物質を放出することもあり、健康への悪影響を及ぼす可能性があります。
適切な湿度管理と換気の重要性
2.適切な湿度管理と換気の重要性
カビ発生を防ぐためには、適切な湿度管理と効果的な換気が欠かせません。まず、湿度計を使用して室内の湿度を定期的に確認しましょう。一般的に、室内の湿度は50%以下を目指すことが推奨されています。湿度が高い場合は、除湿器を利用するなどして湿度を調節しましょう。また、十分な換気を行うことも重要です。定期的に窓を開けて新鮮な空気を取り入れるか、換気扇やエアコンの送風機能を活用して室内の空気を循環させましょう。
水漏れや結露のチェックと修理
水漏れや結露もカビ発生の原因となります。屋内の水道や配管に問題がある場合、水漏れが発生し湿度が上昇します。また、窓や壁、天井などで結露が発生すると、カビが繁殖する土壌となります。定期的に水漏れや結露のチェックを行い、問題があれば早めに修理や改修を行いましょう。また、浴室やキッチンのシーリングやタイルの目地なども定期的に点検し、劣化や浸水の有無を確認し、必要に応じて補修を行いましょう。
カビの発生を防ぐためには、湿度と通気の管理が欠かせません。適切な湿度を保ちながら効果的な換気を行い、水漏れや結露にも注意を払いましょう。次の章では、さらに具体的なカビ対策方法や専門家のアドバイスについてご紹介します。カビ問題に悩む方々にとって、この情報が役立つことを願っています。
専門家によるカビ対策のアドバイス
プロの知識と経験から学ぶ効果的な対策方法
このセクションでは、カビ対策の専門家から得られる貴重なアドバイスについてご紹介します。プロの知識と経験に基づいた効果的な対策方法を学ぶことで、カビ問題に的確に対処し、健康的で快適な住環境を実現しましょう。
プロの診断とカビの種類の特定
カビの種類や発生状況は様々であり、適切な対策方法を選ぶためにはプロの診断が重要です。専門家は熟練した目でカビを判別し、原因や影響範囲を詳しく調査します。カビの種類を特定することで、それに適した対策を立てることができます。
カビの除去方法と適切な処理
カビの除去は正しい方法で行うことが重要です。専門家は適切な防護具を着用し、専用の除菌剤や洗浄方法を用いてカビを根本から除去します。また、除去後の処理も重要であり、残ったカビの再発を防ぐために適切な処置を行います。
長期的な予防策と定期的なメンテナンス
カビの再発を防ぐためには、長期的な予防策と定期的なメンテナンスが欠かせません。専門家は適切な換気や湿度管理、断熱改修などの対策を提案します。さらに、定期的な点検や清掃のスケジュールを立て、早期発見と予防策の継続をサポートします。
カビ対策の専門家からのアドバイスは、正確な診断と効果的な対策の実施に役立ちます。プロの知識と経験に基づいたアドバイスを受けることで、カビ問題に迅速かつ効果的に対応し、健康的な居住環境を保つことができます。お住まいのカビ問題については、専門家にご相談いただくことをおすすめします。
カビ対策に効果的な製品とツールの紹介
便利グッズでカビ問題を解決しよう
カビ対策には、効果的な製品やツールの活用が欠かせません。この章では、カビ問題の解決に役立つ便利なグッズを紹介します。これらのアイテムを使うことで、カビの除去や予防がスムーズに行えるようになります。さまざまな製品やツールの活用法を学び、快適な住環境を取り戻しましょう。
カビ除去剤や防カビシートの活用法
カビ除去剤は、カビの発生した箇所に直接スプレーすることで、効果的にカビを除去することができます。適切な除去剤を選び、使用方法を守って使いましょう。また、防カビシートは、カビが発生しやすい場所に貼ることで、カビの繁殖を防止します。シートの貼り方や交換のタイミングに注意しながら、効果的に活用しましょう。
除湿機や空気清浄機の役割と選び方
湿度の高い環境はカビの発生を促します。そのため、除湿機の活用はカビ対策に有効です。除湿機は空気中の湿気を取り除き、室内の湿度を適切なレベルに保つことができます。また、空気清浄機もカビ対策に役立ちます。空気清浄機は、カビの胞子や微粒子を取り除くことで、室内の空気を清潔に保つことができます。適切な除湿機や空気清浄機の選び方や使用方法についても学んでおきましょう。
防カビ塗料やシーリング剤の利用
防カビ塗料やシーリング剤は、カビの発生を予防するために使用されます。防カビ塗料は壁や天井に塗布することで、カビの繁殖を防止します。また、シーリング剤は水回りや風呂場などの目地に使われ、湿気の侵入を防ぎます。適切な塗料やシーリング剤の選び方や施工方法について理解し、適時に利用しましょう。
これらの製品やツールは、カビ対策において有効な手段となります。ただし、正しい使い方や適切なタイミングでの利用が重要です。製品の説明書や専門家のアドバイスを参考にしながら、効果的なカビ対策を行いましょう。
カビ対策の日常生活への取り組み
健康な住環境を維持するための習慣と工夫
カビ対策は日常生活の中で継続的に行うことが重要です。健康な住環境を維持するためには、掃除の頻度や方法の改善、適切な収納と湿気の管理、室内の空気循環と換気の促進など、さまざまな習慣と工夫が求められます。以下では、それぞれのポイントについて詳しく説明します。
掃除の頻度と方法の改善
カビの発生を予防するためには、定期的な掃除が欠かせません。特に湿気の多い場所やカビの発生しやすい箇所は重点的に掃除しましょう。掃除の際には適切な洗剤やカビ除去剤を使用し、隅々まで丁寧に清掃します。また、掃除後は十分に乾燥させることも重要です。
適切な収納と湿気の管理
カビは湿度が高い環境で繁殖しますので、収納や湿気の管理にも注意が必要です。衣類や布団などの収納には風通しの良い場所や除湿剤を活用し、湿気を適切に管理しましょう。また、キッチンや浴室などの水回りでは、使用後にしっかりと乾燥させることが重要です。
室内の空気循環と換気の促進
室内の空気循環を良好に保つこともカビ対策の一環です。定期的に窓を開けて換気を行い、新鮮な空気を取り入れましょう。特に湿度が高い梅雨や夏季などは注意が必要です。また、室内には空気清浄機を設置することで、ホコリやカビの胞子などを取り除く効果も期待できます。
日常生活におけるこれらの取り組みは、カビの発生を予防し、健康な住環境を維持するために欠かせません。継続的な注意と努力が必要ですが、これらの習慣と工夫を取り入れることで、カビに悩まされることなく快適な生活を送ることができるでしょう。また、カビ対策に関する情報や相談は専門家にもご相談いただくことをおすすめします。
カビ問題の専門家への相談とサポート
プロのアドバイスで確実な解決を
カビ問題は一度発生すると根深く広がる可能性があり、素人の対処では完全な解決が難しいことがあります。そんな時に頼りになるのがカビ対策の専門家です。専門家は豊富な知識と経験を持ち、確実な解決策を提供してくれます。この記事では、カビ問題の専門家への相談とサポートの重要性について探っていきます。
カビバスターズの専門家によるカビ診断
カビ問題を解決するためには、まず正確な診断が必要です。カビバスターズでは、専門家が現地調査を行い、カビの原因や状況を的確に把握します。専門家は豊富な知識と経験に基づき、問題の根本原因を特定し、最適な対策を提案してくれます。カビの種類や広がり具合に応じて、適切な処理方法や予防策をアドバイスしてもらえます。
カビ対策のカスタマイズとトラブルシューティング
カビの問題は、状況や環境によって異なる場合があります。専門家は個別のケースに合わせてカビ対策をカスタマイズします。例えば、特定の部屋やエリアでのカビ発生の原因や再発防止策を提案してくれます。また、カビ対策の実施中に生じたトラブルや疑問に対しても迅速に対応してくれます。専門家のアドバイスにより、効果的なカビ対策を実施することができます。
継続的なアフターケアとフォローアップ
カビ対策は一度行ったからと言って終わりではありません。定期的なメンテナンスやアフターケアが重要です。専門家は継続的なサポートを提供し、効果の持続性を確保します。定期的なチェックや点検により、新たなカビ発生のリスクを低減することができます。また、トラブルや不安があればいつでも相談できるため、安心して快適な住環境を維持することができます。
カビ問題は放置すると健康被害や建物の劣化など様々な問題を引き起こす可能性があります。そのため、専門家の知識と経験を頼りにすることは非常に重要です。カビバスターズのような専門業者に相談することで、確実な解決策が見つかり、健康で快適な住環境を取り戻すことができます。お住まいのカビ問題に関しては、ぜひ専門家への相談とサポートをご活用ください。
カビ対策施工事例とお客様の声
実際の現場での解決事例と喜びの声
カビは住宅や建物にとって深刻な問題ですが、幸いにもカビバスターズの専門家が数多くの施工事例で問題を解決してきました。この記事では、実際の現場で行われたカビ対策施工の事例と、お客様から寄せられた喜びの声を紹介します。その実績と満足度の高さから、カビバスターズがカビ問題における信頼できるパートナーであることが伝わることでしょう。
実際にカビ問題を解決した体験談
実際の施工事例では、さまざまなタイプのカビ問題が取り上げられます。例えば、浴室のカビやキッチンのシロアリ被害とカビの関連、または屋根や壁など建物の外部に生じるカビ被害などです。具体的な事例を通じて、どのようなカビ問題が解決され、どのような手法や製品が使用されたのかをご紹介します。お住まいや建物の状況に合わせて施工された対策がどのように効果を発揮したのか、実例を通じて具体的にご説明いたします。
カビバスターズのサービスによる効果と満足度
お客様から寄せられた喜びの声は、カビバスターズの施工品質とサービスの質の高さを証明しています。お客様は、カビ問題が解決し、住環境が改善されたことで安心感や快適さを得ています。特に、専門家による丁寧なカビ診断とカスタマイズされた施工が、お客様のニーズに合致していたとの声が多く寄せられています。また、施工後のアフターケアやフォローアップも行き届いており、お客様の満足度は非常に高いです。カビバスターズが提供するサービスの効果と、お客様が感じた満足度の詳細をご紹介します。
カビ問題に直面している方々にとって、実際の事例やお客様の声は大変参考になるものです。カビバスターズの専門知識と経験がどのようにカビ問題の解決に貢献しているのか、またお客様の声からは信頼性や満足度の高さが伝わってきます。これらの事例や声を通じて、カビバスターズがカビ問題における頼れるパートナーであることを実感していただければ幸いです。
カビ対策の今後のトレンドと最新情報
住環境の健康と持続可能性への取り組み
カビ対策は、快適で健康的な住環境を維持するために重要な要素です。現在、カビ対策の分野では新たな技術や製品の開発が進んでおり、持続可能な取り組みも注目を集めています。この章では、カビ対策の今後のトレンドと最新情報について探っていきましょう。
新たな技術や製品の開発と導入
カビ対策の分野では、常に新たな技術や製品の開発が行われています。例えば、カビの発生を抑制する特殊なコーティング剤や、カビの成長を阻害する素材の研究が進んでいます。また、高効率なカビ除去装置や自動化システムの開発も進んでおり、効果的なカビ対策がより容易になる可能性があります。これらの新たな技術や製品の導入により、より効果的で持続可能なカビ対策が実現されることが期待されています。
環境にやさしいカビ対策の取り組み
カビ対策の重要な要素の一つは、環境に配慮した取り組みです。従来のカビ対策では、化学薬品や強力な殺菌剤が使用されることがありましたが、これらは環境への負荷や健康への影響が懸念されます。最近では、環境にやさしいカビ対策のために、自然素材や微生物を活用した方法が注目されています。例えば、天然の抗菌・抗カビ効果を持つ植物エキスや、生物学的なカビ制御方法が開発されています。これにより、環境への負荷を軽減しつつ、効果的なカビ対策を実現することが可能となります。
カビ対策の今後のトレンドと最新情報を把握することは、より効果的な対策を取るために重要です。新たな技術や製品の開発により、カビ対策はより効率的かつ持続可能なものに進化していくでしょう。また、環境への配慮も重要な要素となります。環境にやさしいカビ対策の取り組みが進むことで、健康な住環境の維持と地球環境の保護が両立することが期待されます。今後のカビ対策の動向に注目し、最新の情報を取り入れながら、より良い住環境を実現しましょう。
今すぐ始めるためのアクションプラン
カビ問題解決への道筋と実践手順
カビ問題は住環境と健康に深刻な影響を及ぼす可能性があります。この章では、カビ対策の重要性を再確認し、実践的な手順を提供します。カビの発生を防ぐためのアクションプランを立て、快適な住環境と健康を取り戻しましょう。
【1. カビ対策の重要性を再確認しましょう】
カビは見た目の問題だけでなく、健康被害や建物への損害を引き起こす可能性があります。この節では、カビ対策の重要性を再確認し、なぜ早めの対策が必要なのかについて詳しく説明します。カビの影響がどのように広がるかを理解し、その深刻さを認識しましょう。
【2. 専門家のアドバイスを活用して対策を立てる】
カビ問題の解決には専門家のアドバイスとサポートが不可欠です。このセクションでは、カビバスターズの専門家が提供する価値あるアドバイスを活用しましょう。カビの診断と種類の特定から始め、適切な除去方法と処理手順を学びましょう。専門家の知識と経験を頼りに、最適な対策プランを立てましょう。
【3. 快適な住環境と健康を取り戻すためのステップ】
カビ問題を解決し、快適な住環境と健康を取り戻すためには、具体的なステップを踏む必要があります。この節では、以下の手順を詳しく説明します。
・高湿度環境の管理と通気改善:適切な湿度管理と効果的な換気方法を実践しましょう。
・水漏れや結露のチェックと修理:建物の構造や配管に問題がないかを確認し、必要な修理を行いましょう。
・カビ対策製品の活用:カビ除去剤、防カビシート、除湿機、空気清浄機など、効果的な製品とツールを適切に使用しましょう。
・日常生活の改善:掃除の頻度と方法の改善、適切な収納と湿気の管理、室内の空気循環と換気の促進など、日常生活の習慣や工夫を取り入れましょう。
これらの手順を実践することで、カビ問題を解決し、健康で快適な住環境を実現することができます。早めの対策と継続的なメンテナンスが重要です。今すぐアクションプランを立て、カビ問題に取り組みましょう。
------------------------------------------------------------------------------------------------------------------------
カビ取り・カビ対策専門業者MIST工法カビバスターズ本部
0120-052-127(平日9時から17時)
カビの救急箱
【検査機関】
一般社団法人微生物対策協会
------------------------------------------------------------------------------------------------------------------------